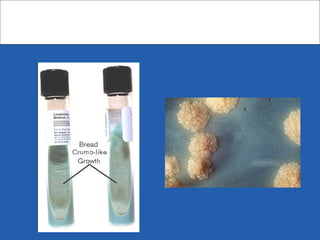

El género Mycobacterium se compone de bacilos aerobios inmóviles con una pared celular rica en lípidos, lo que les confiere resistencia a desinfectantes y tinciones, siendo clasificados como bacilos ácido-alcohol resistentes. Las micobacterias pueden causar diversas enfermedades, siendo la tuberculosis la más prevalente, afectando a una gran parte de la población mundial y representando un importante problema sanitario, especialmente en individuos inmunodeprimidos. Su diagnóstico se basa en técnicas como la baciloscopía y cultivos, y el tratamiento enfrenta desafíos debido a la resistencia a fármacos.